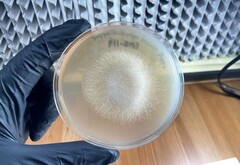
Mucor circinelloides
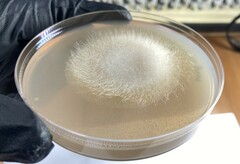
Mucor circinelloides
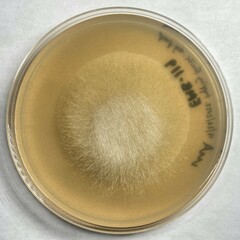
Mucor circinelloides
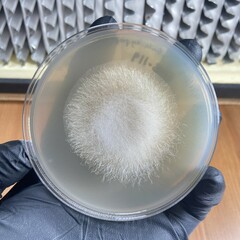
Mucor circinelloides

Mucor circinelloides: taxon details and analytics
- Domain
- Kingdom
- Fungi
- Phylum
- Zygomycota
- Class
- Mucoromycetes
- Order
- Mucorales
- Family
- Mucoraceae
- Genus
- Mucor
- Species
- Mucor circinelloides
- Scientific Name
- Mucor circinelloides
Images from inaturalist.org observations:
We recommend you sign up for this excellent, free service.
Parent Taxon
Sibling Taxa
- Mucor abundans
- Mucor bainieri
- Mucor caninus
- Mucor circinelloides
- Mucor ctenidius
- Mucor echinatus
- Mucor exponens
- Mucor guilliermondii
- Mucor hiemalis
- Mucor juglandis
- Mucor laxorrhizus
- Mucor luteus
- Mucor mousanensis
- Mucor mucedo
- Mucor murinus
- Mucor piriformis
- Mucor plumbeus
- Mucor racemosus
- Mucor saturninus
- Mucor strictus
- Mucor taeniae
- Mucor tofus
- Mucor tuberculisporus
- Mucor variosporus